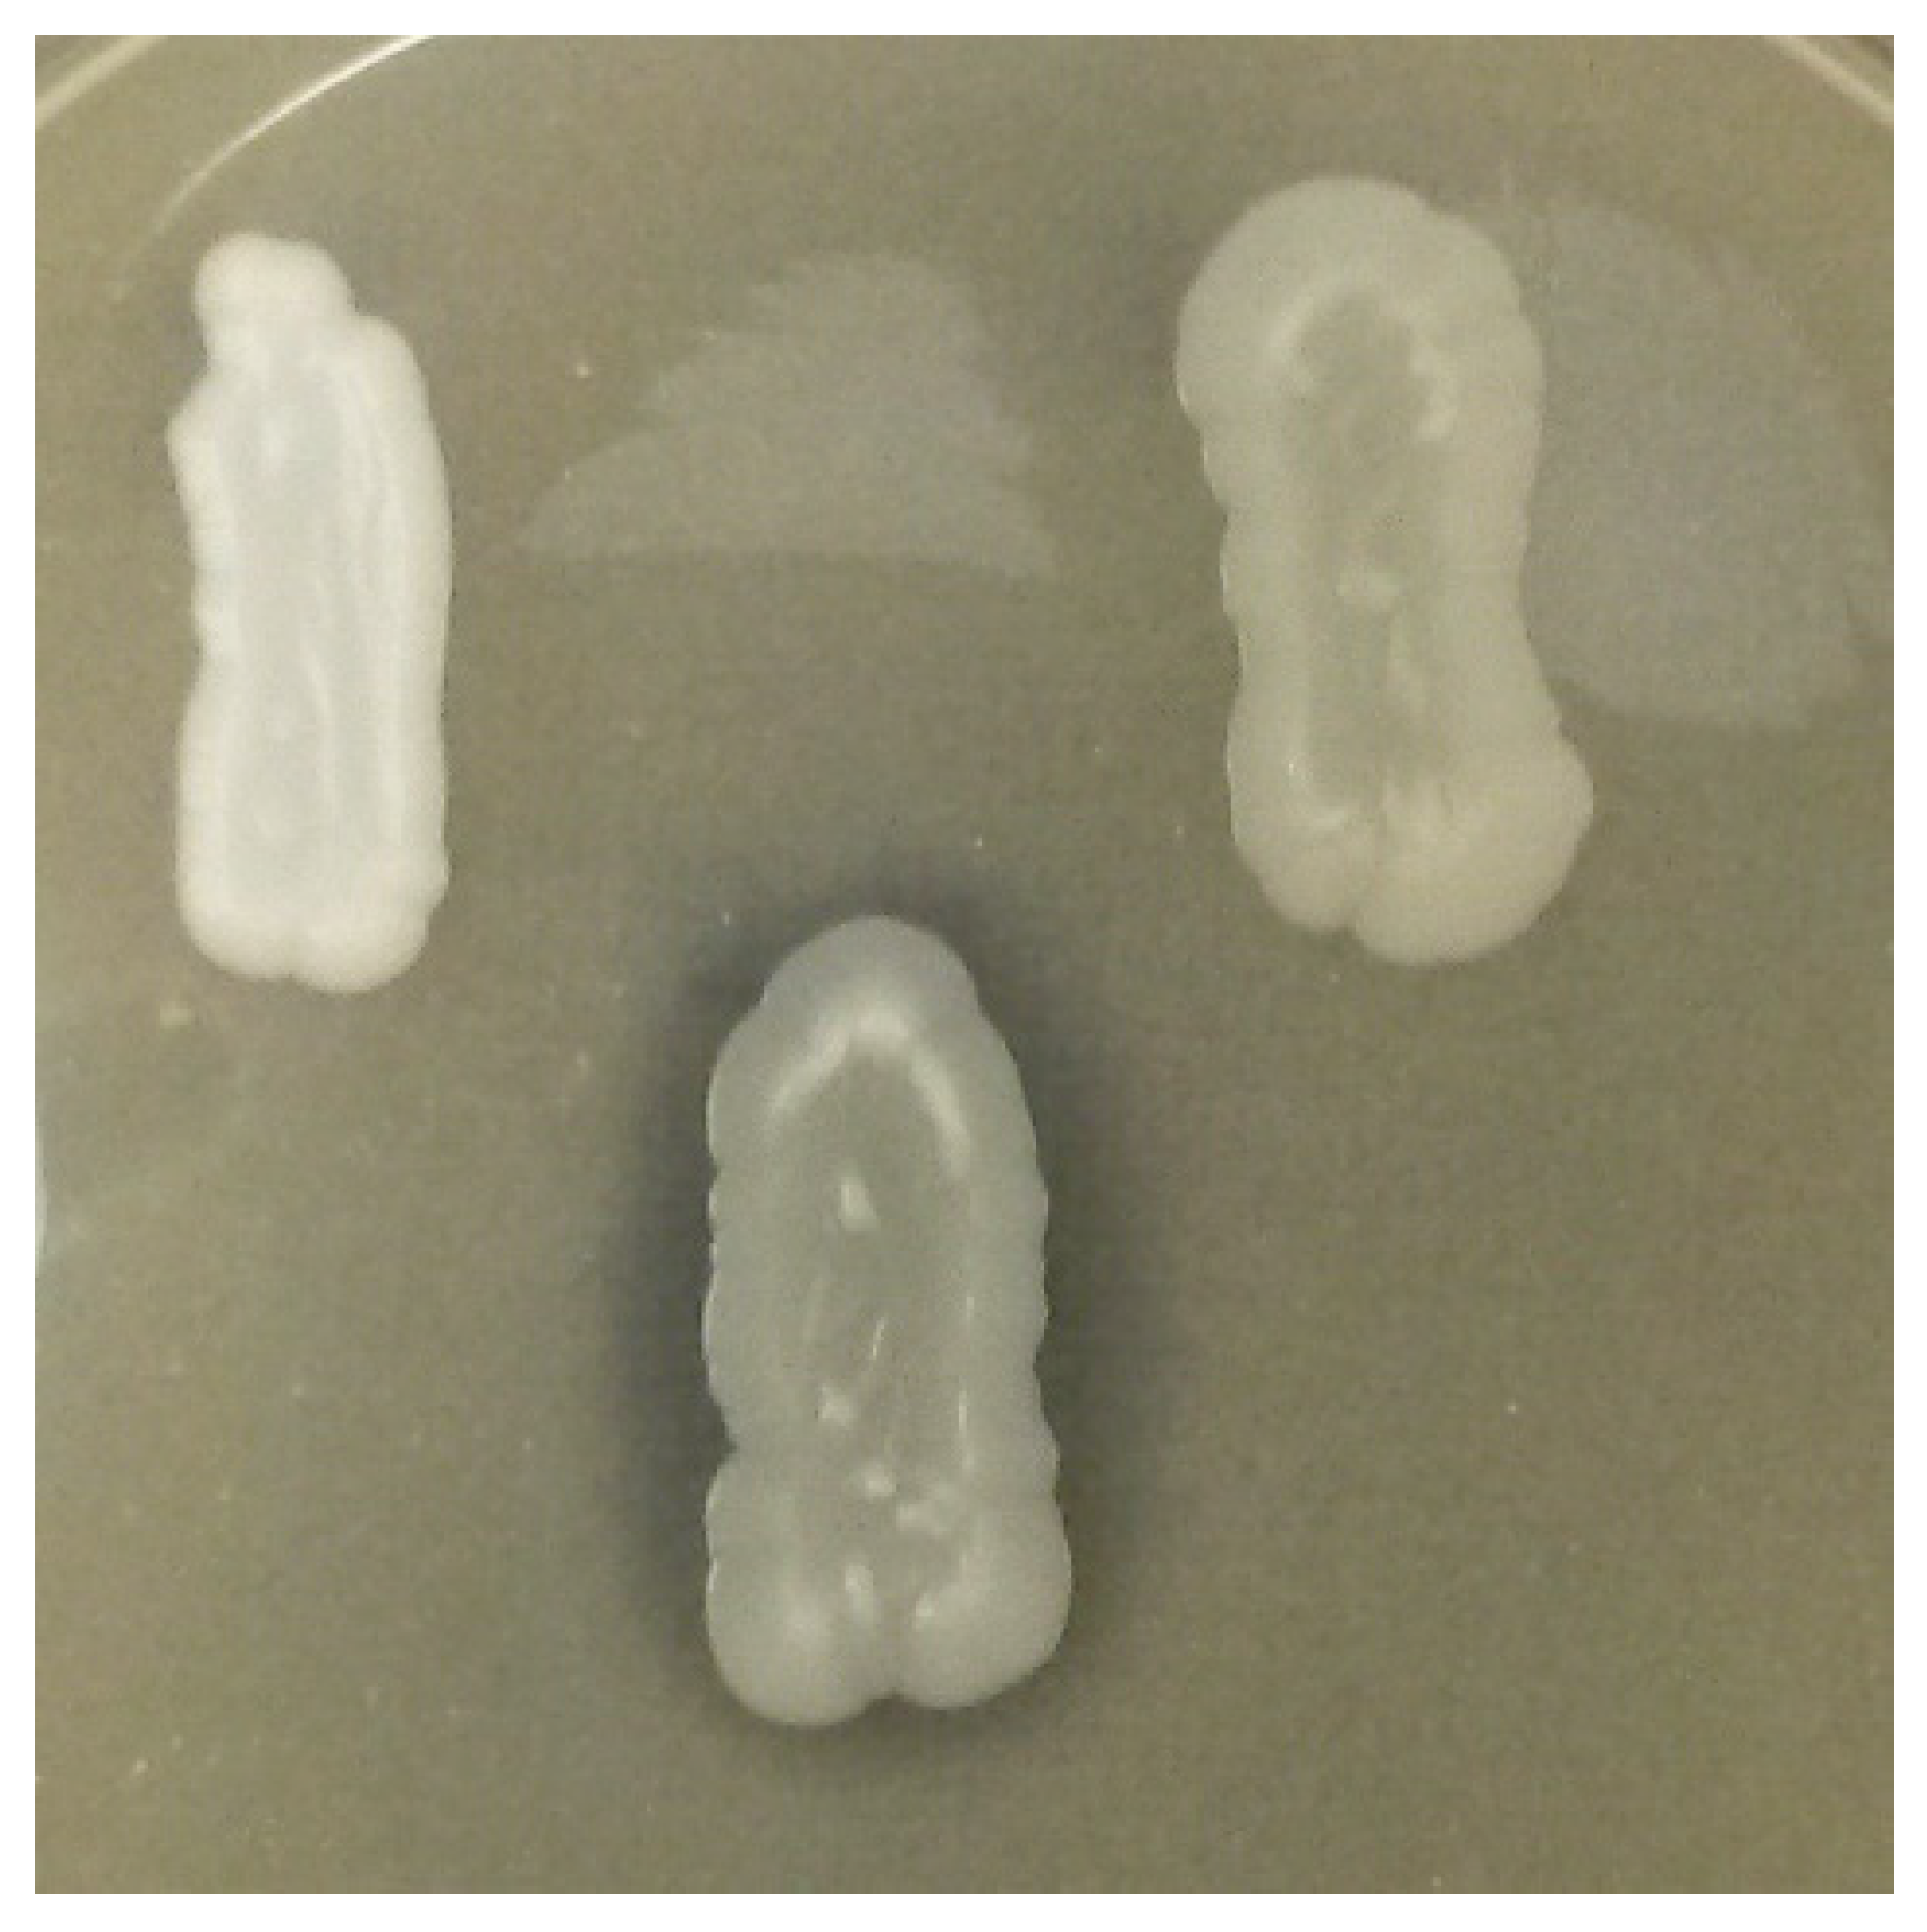
Microorganisms 09 02223 g004
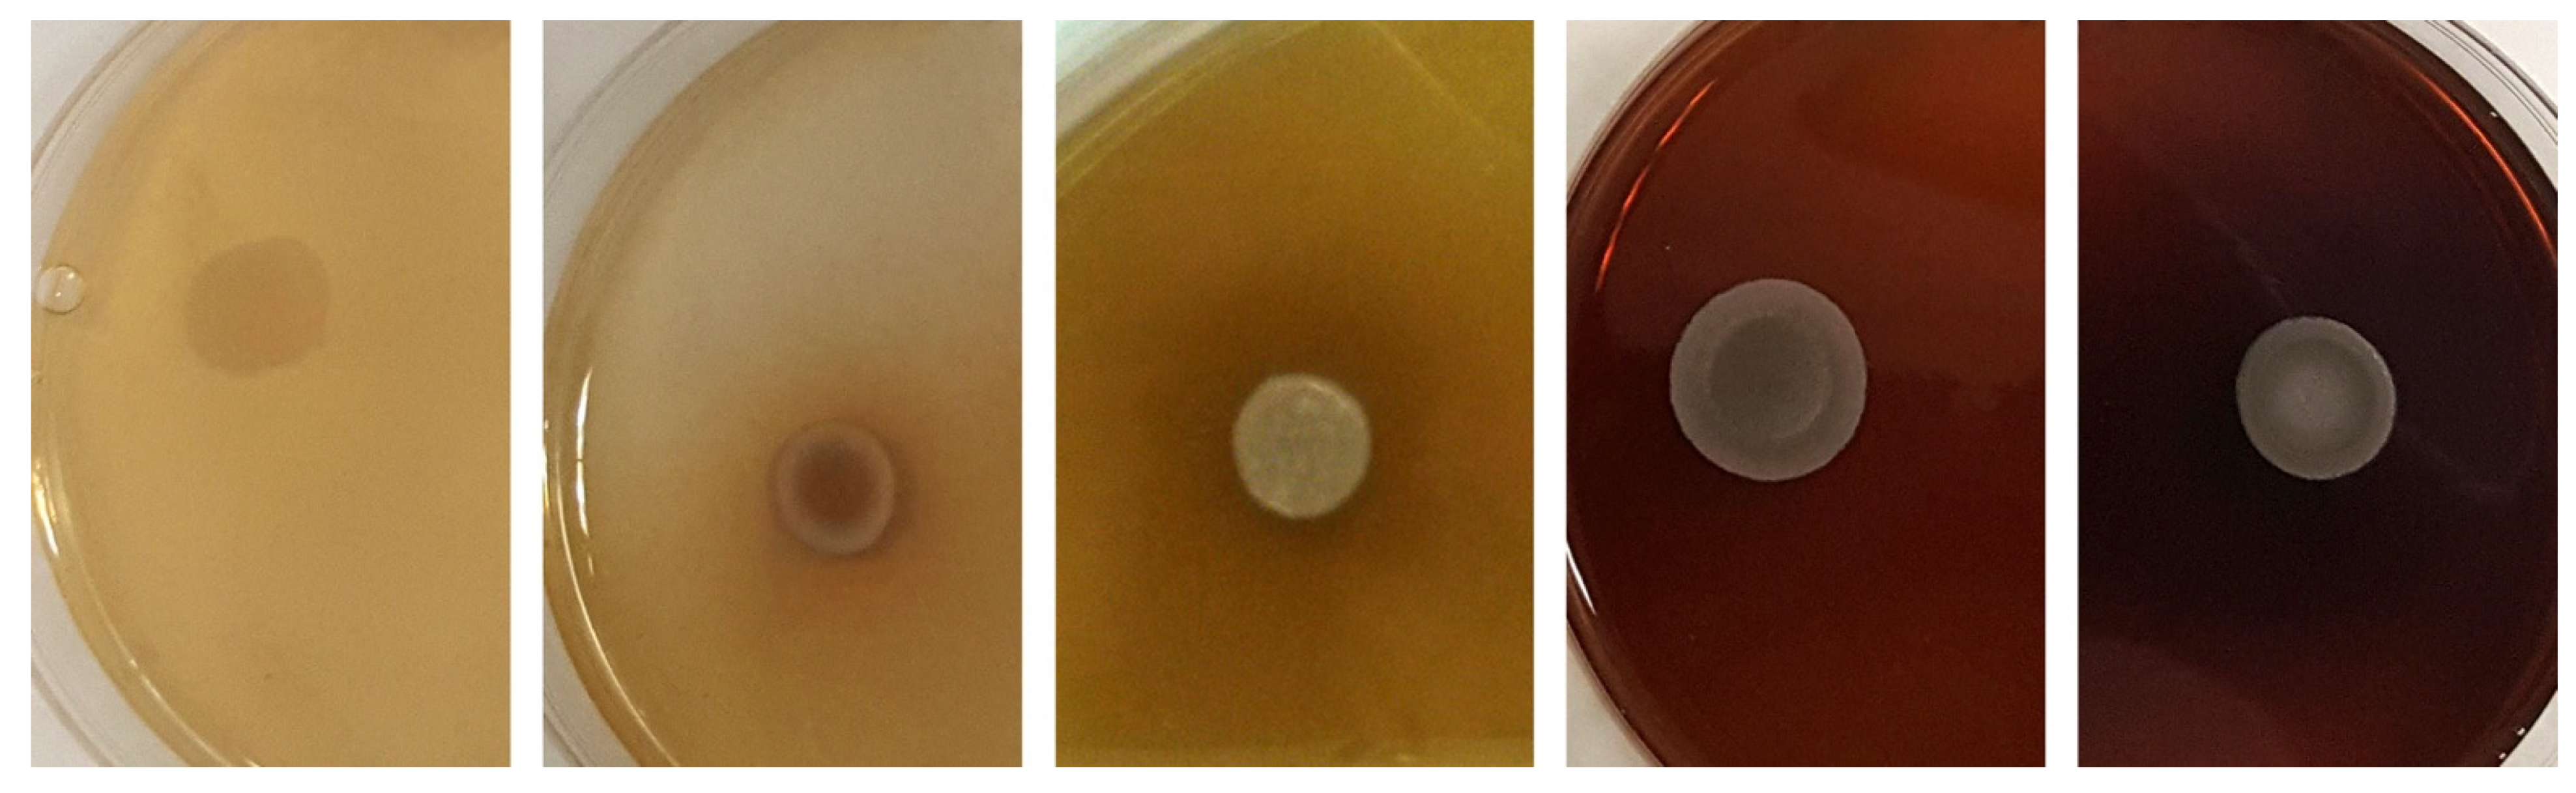
Microorganisms 09 02223 g006
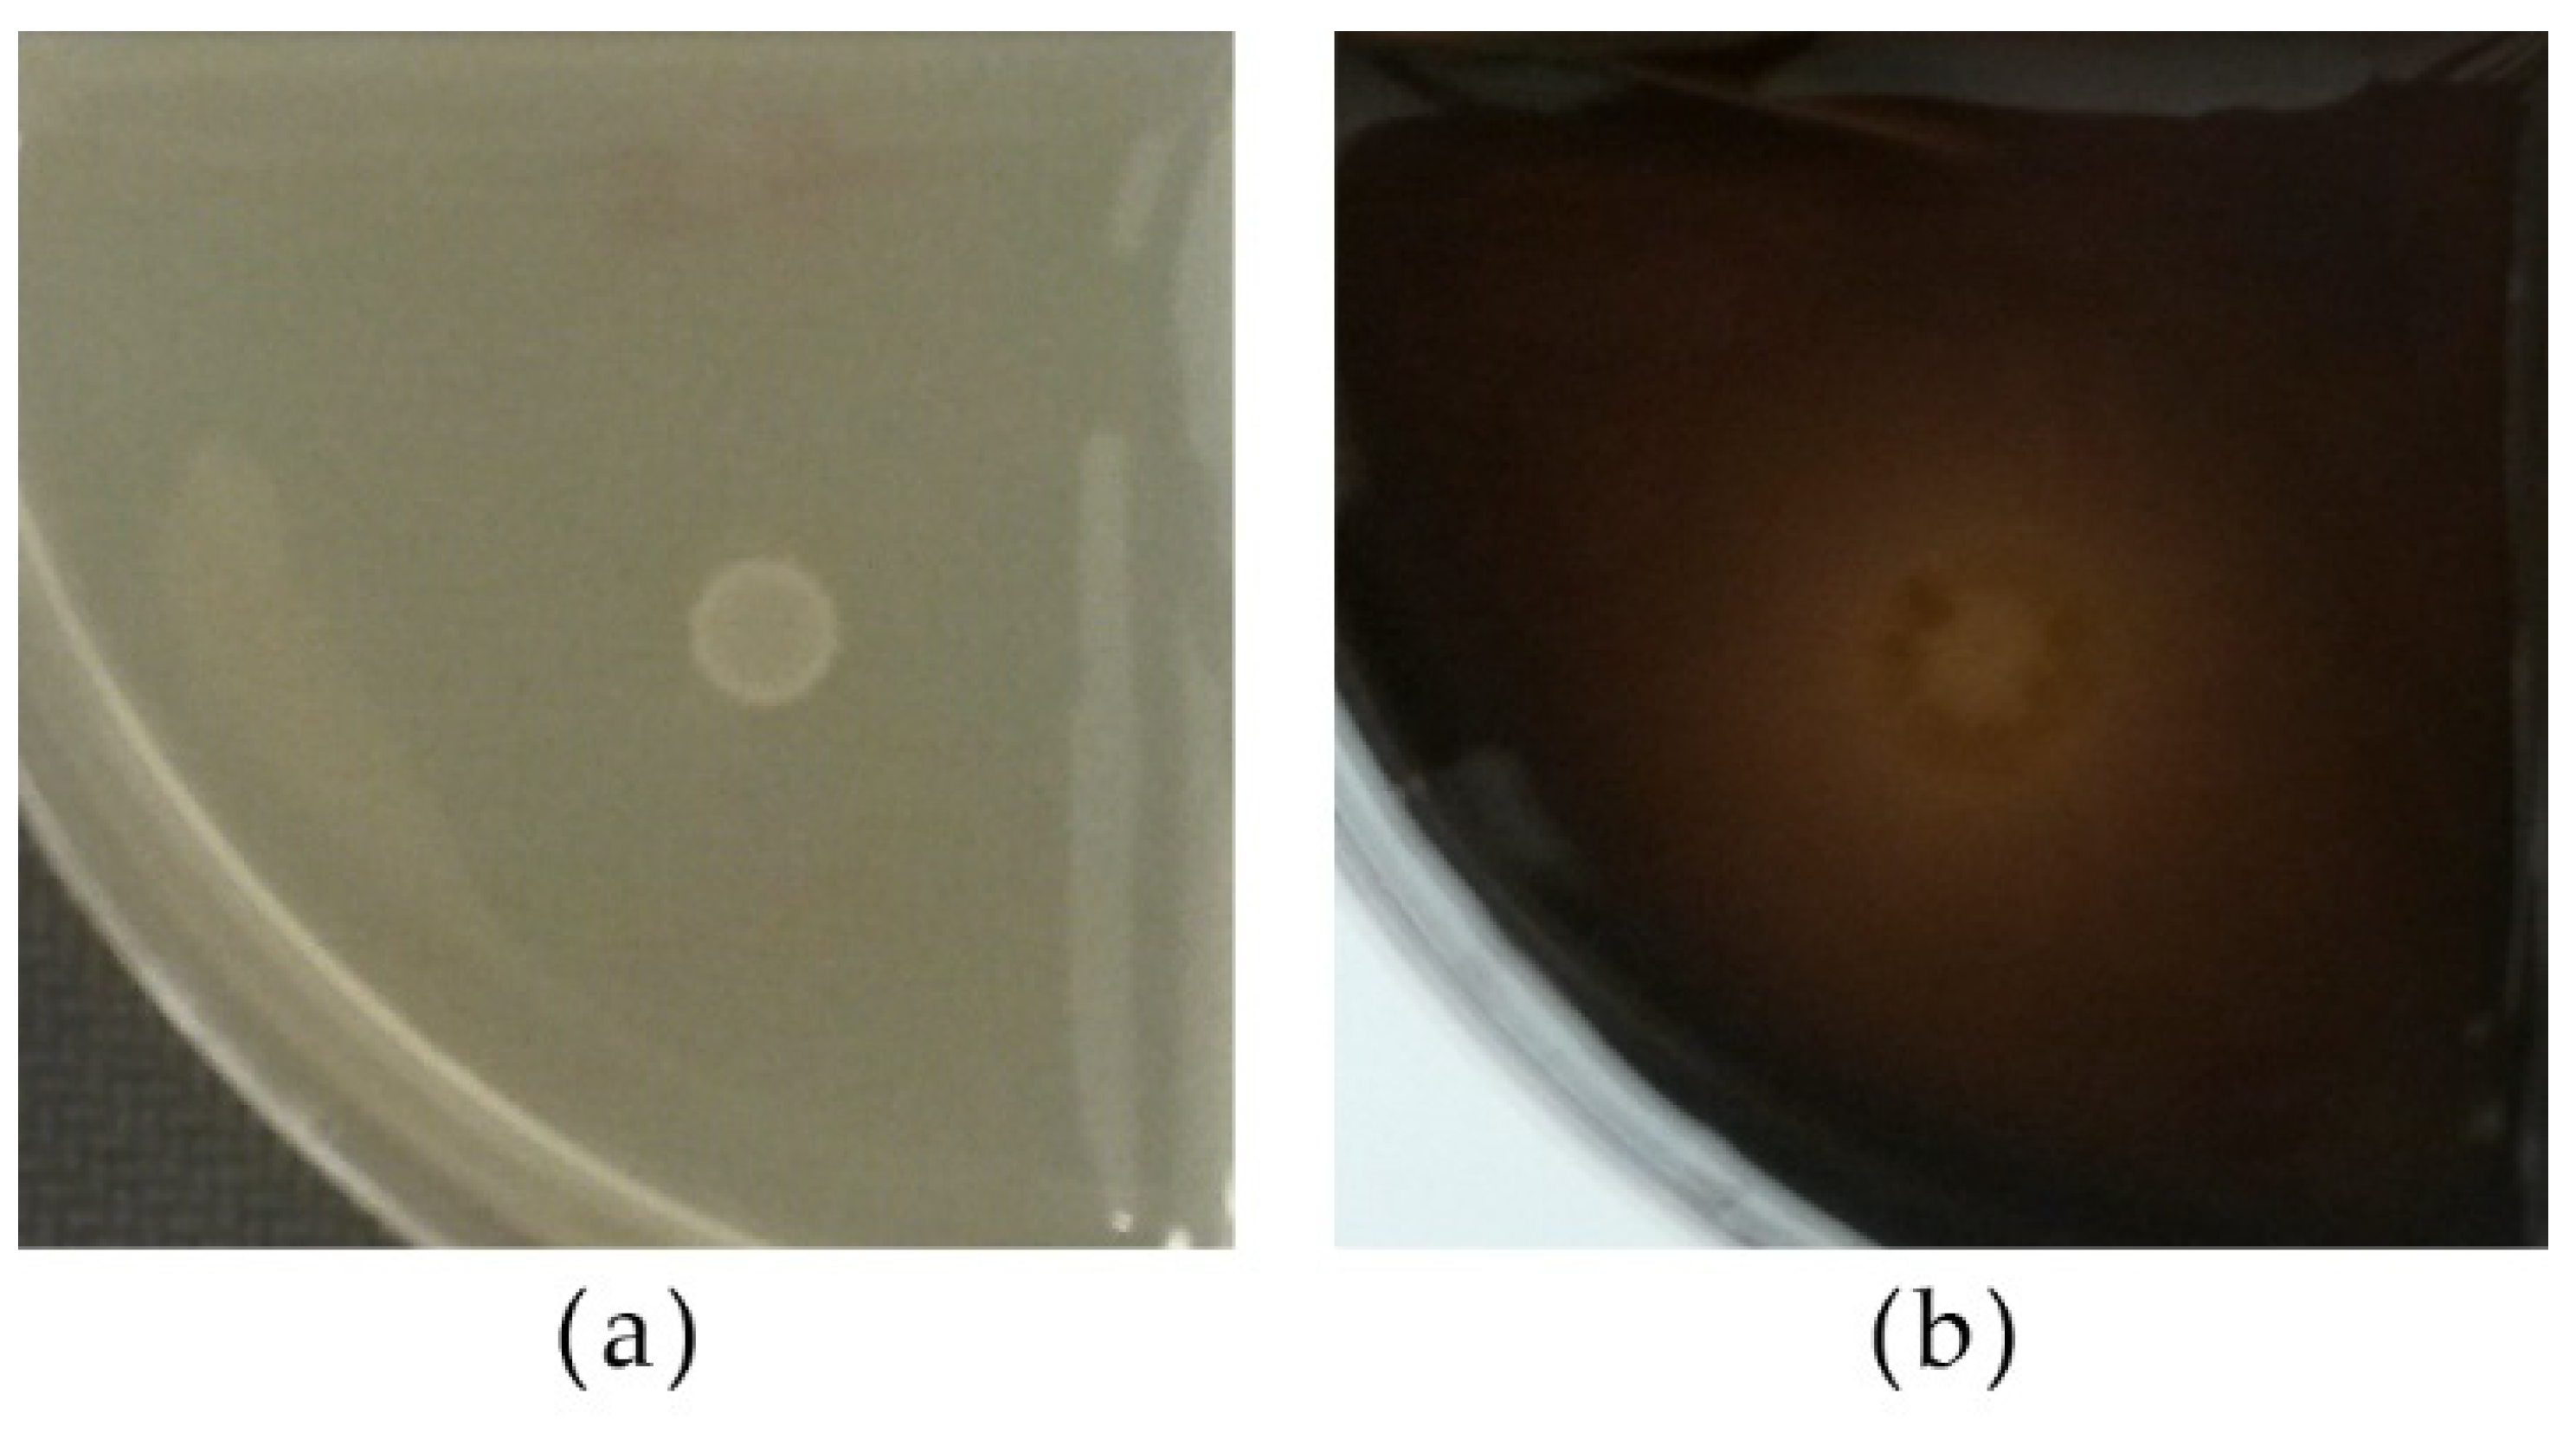
Microorganisms 09 02223 g007
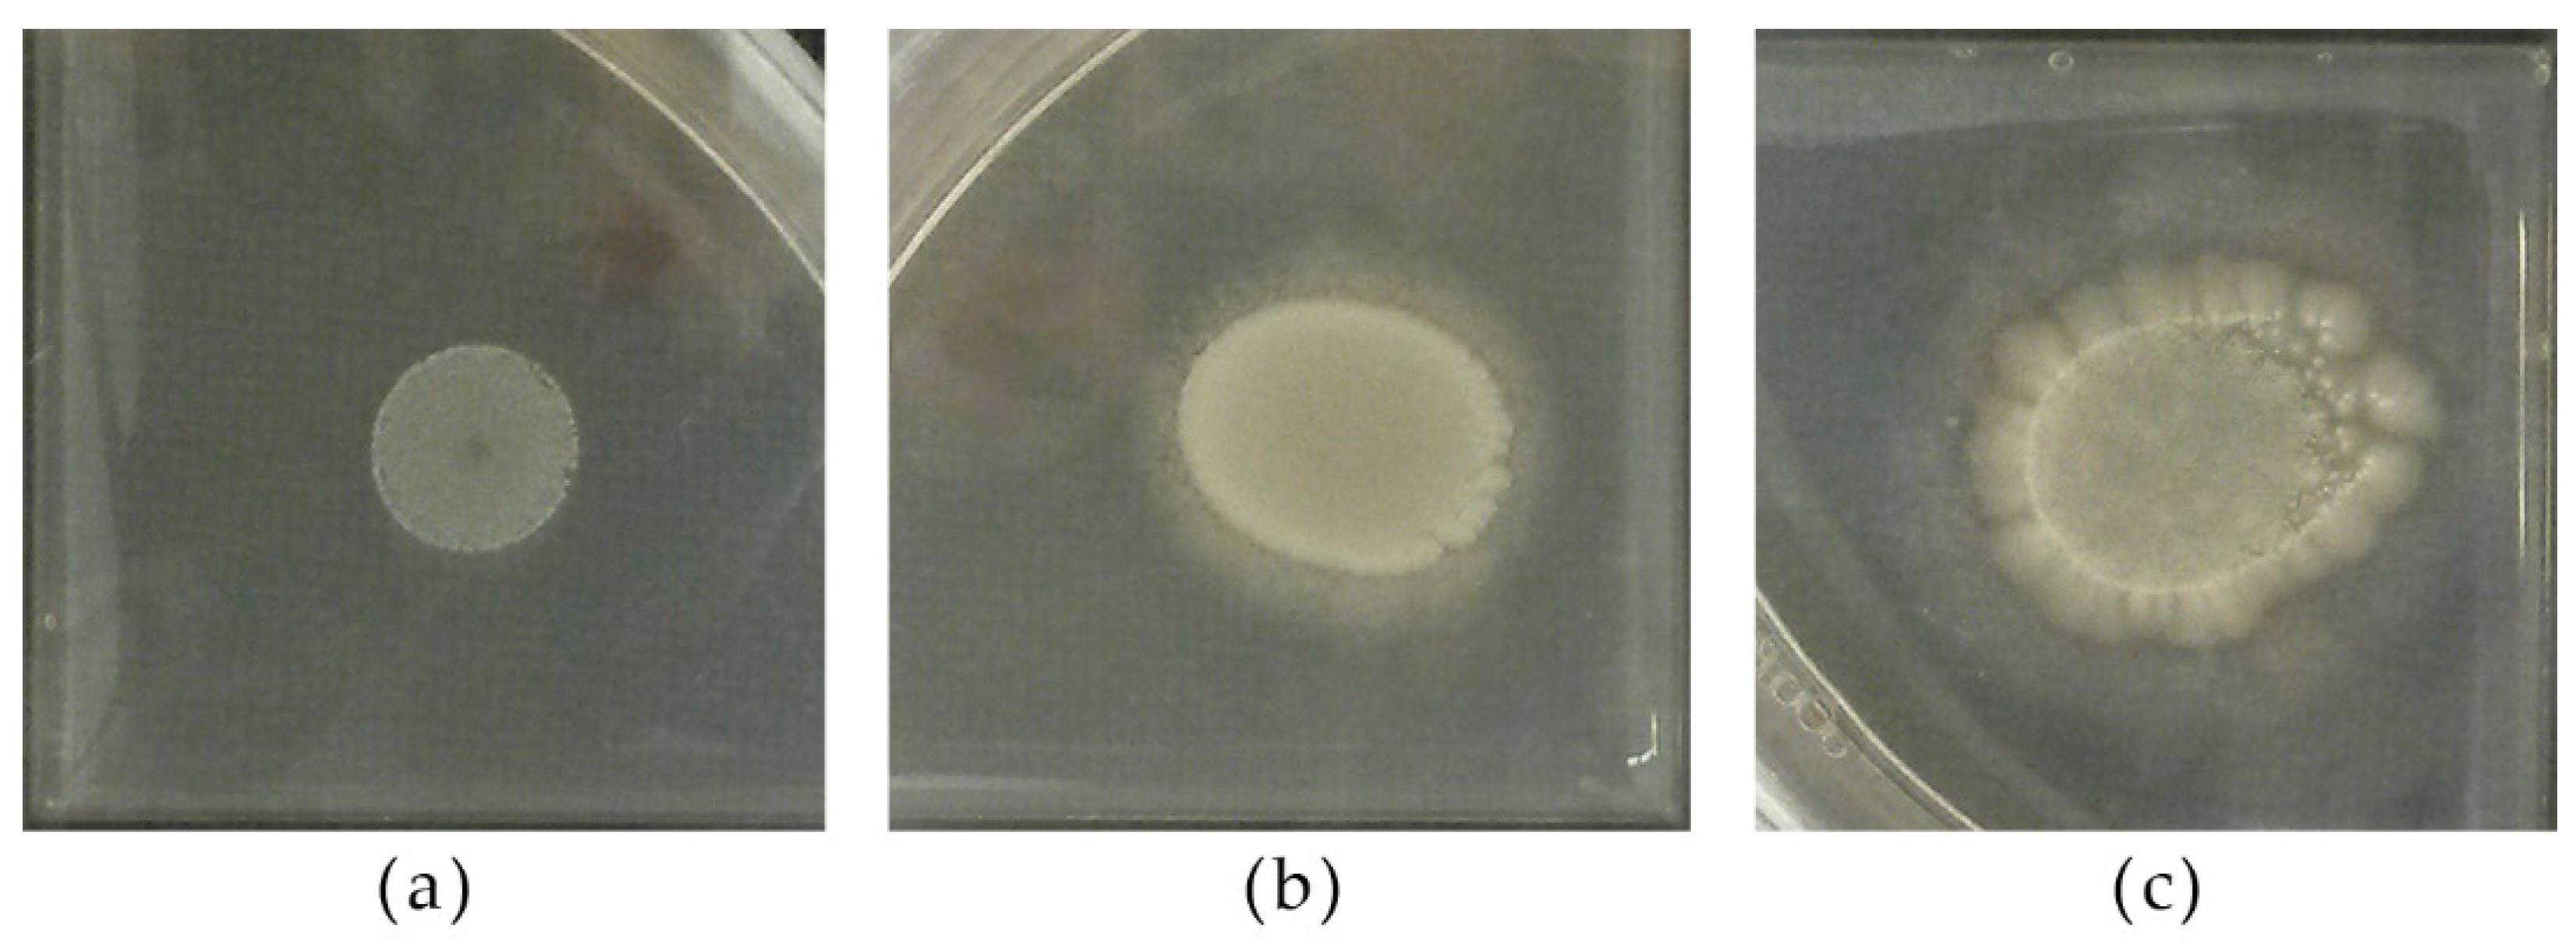
Microorganisms 09 02223 g008

1. Introduction
Wine reflects the specificity of a
terroir, including the microbial
terroir [
1]. This is particularly true in spontaneous fermentation by native wine yeasts that nevertheless expose winemakers to well-known complications. Most winemakers prefer to make use of commercial
Saccharomyces cerevisiae starters, which guarantee predictability and reproducibility of the wines. On the other hand, the extensive use of worldwide-distributed commercial starters leads to organoleptic flattening and uniformization of the wines. Moreover, the positive contribution of non-
Saccharomyces strains to must fermentation is well established. Non-
Saccharpmyces species are known to modulate the wine aromatic profile in particular via esterase and β-glucosidase activities, but also to increase the glycerol content, to lower the alcohol content, and to exert proteolytic and pectinolytic activities that lead to enrichment of the aroma profile [
2,
3,
4,
5,
6,
7,
8]. Besides
S. cerevisiae commercial starters, non-
Saccharomyces commercial starters have become available in recent years [
9].
An alternative for preserving the role of the microbial terroir is to isolate and select autochthonous Saccharomyces and non-Saccharomyces strains towards optimal enological characteristics for use as co- or sequential inocula for wine production in the area from which they were isolated.
Enological characteristics to consider in the selection process are divided into technological and qualitative traits [
10]. Technological traits (fermentation vigor, ethanol tolerance, resistance to SO
2, type of growth in liquid media, growth at high and low temperatures) are characteristics useful for efficient fermentation, while qualitative traits refer to those that influence chemical and sensorial composition and properties of wine (acetic acid and sulfuric compound production, production of volatile compounds connected with pleasant notes or off-flavors, enzymatic activities).
The enological characteristics reported above are important for the selection of
Saccharomyces cerevisiae strains, but they are also useful for studying non-
Saccharomyces yeasts. It appears crucial to have a complete overview of the traits of yeast strains to select those possessing the best abilities for must fermentation. Moreover, when choosing strains it is necessary to consider the technology of production and the type of product (wines, sparkling wines, botrytized high-sugar wines) where the selected strains will be applied [
11,
12,
13,
14,
15,
16].
Isolation of autochthonous microorganisms in various countries and wine-production regions with the aim of developing region-specific wine starters continues to be attractive [
17]. Such research requires sensitive, relevant, and effective scientific methods to assess genetic, biochemical and technological traits characterizing the potential of microorganisms to be used in wine production. In recent years, various new approaches for enological yeast selection have been reported, while others have been optimized or updated [
18,
19,
20,
21]. The number of tests used to screen wine strains ranges from a few to many. As examples, colony morphology [
22], ethanol resistance [
23,
24,
25,
26,
27,
28], SO
2 resistance [
23,
25,
26,
27,
28,
29], H
2S [
22,
25,
26,
27,
28,
29,
30,
31], enzymatic properties [
22,
26,
27,
28,
29,
32,
33], resistance to osmotic stress [
24,
26,
27], acetic acid production and spore formation [
31], growth at various temperatures [
24], fermentation vigor [
31], and gas production [
27] have been investigated. Molecular biology approaches were also developed in order to identify and cluster isolated wine yeasts [
34,
35], and also to screen the yeast communities in wine-related samples through the analysis of the total extracted DNA and RNA [
36,
37,
38]. The latest methods involve very productive scientific tools in genetics and taxonomy but have been found to be unable to replace the more traditional microbiological methods.
To the best of our knowledge, there is a lack of a digest reporting all of the main microbiological methods, including images, to use for selecting wine yeast strains. This paper provides a compendium of up-to-date, complementary, and reliable methods for this purpose, including an outline of an experimentally verified approach for results evaluation and synthesis of conclusions.
The aim of this work was to provide this compendium of methodologies and images to select wine yeasts based on studies of our own isolates. Through assessing the main technological and qualitative enological strain characteristics using media and grape must micro-fermentations, one Saccharomyces—S. cerevisiae PDA W 10—and two non-Saccharomyces—Lachancea thermotolerans 5-1-1 and Metschnikowia pulcherrima 125/14—strains were selected as potential wine starters.
3. Results
3.1. Yeast Strains Grouping and Identification
Table 2 reports the grouping of strains via 5.8-ITS rRNA analysis and RFLP and their molecular identification by sequencing and comparison with the GenBank database.
The ITS amplicons had sizes ranging from 380 to 800 bp. Eighteen RFLP patterns were observed; different profiles were also assigned to strains belonging to the same species (H. uvarum, L. thermotolerans, M. pulcherrima, P. fermentans, T. delbrueckii, S. cerevisiae).
From among the twenty-nine yeast isolates, five were identified as M. pulcherrima, five as T. delbrueckii, five as S. cerevisiae, three as H. uvarum, three as P. fermentans, two as L. thermotolerans, one as Candida dubliniensis, one as Debaryomyces hansenii, one as Metschnikowia aff. chrysoperlae, one as Meyerozyma guilliermondii, one as Pichia kluyveri, and one as Zygosaccharomyces bailii.
The accession numbers of the yeast strains sequenced and deposited to GenBank are: MZ207954 C. dubliniensis CCY 29-178-1, MZ207959 D. hansenii 5-1-6, MZ207966 H. uvarum 9-2-1, MZ207967 H. uvarum 67/14, MZ207960 L. thermotolerans 5-1-1, MZ207958 L. thermotolerans 5-1-3, MZ207961 M. aff. crysoperlae 11-1-4, MZ207962 M. pulcherrima 11-1-5, MZ207963 M. pulcherrima 11-1-7, MZ207955 M. pulcherrima 125/14, MZ207969 M. guilliermondii 12-5-1, MZ207968 P. fermentans 12-4-4, MZ207970 P. kluyveri PDA W 9, MZ207956 S. cerevisiae 60/16, MZ207957 S. cerevisiae 15-1-552, MZ207953 T. delbrueckii 3-16-1, MZ207964 T. delbrueckii 21-1-5, MZ207965 Z. bailii 24-1-25.
Figure 1 reports the clustering of the strains obtained from the FTIR analysis. The mid-infrared range of 4000–500 wavelength/cm
2 (25,000–2500 nm) is used to excite atoms in molecular bonds, causing them to vibrate. A spectrum can be measured and calculated by light absorption. This specific absorption is then attributed to cell components (e.g., polysaccharides, fatty acids, proteins, mixed region, fingerprint region) [
52] used for identification [
53]. To enhance the resolution of complex bands and to minimize difficulties evolving from inevitable baseline shifts, the second derivations of the original spectra were calculated. This made it possible to obtain a list of the most similar spectra from the database [
54], leading to identification at the species level.
Isolates were classified into sub-clusters by defining a spectral distance as a value for separation on the strain level. The spectral distance chosen was 0.1. The grouping reported in the figure closely corresponds to the results obtained from sequencing.
3.2. Yeast Colonies, Cells, and Spores Characteristics
Table 3 reports the morphology, color, and texture of the colonies of the different strains grown on YPD agar. The strains belonging to the
Metshnikowia genus exhibited biomass turning red during the prolonged incubation time.
The microscopic morphologies of strains belonging to the species chosen as representative are reported in
Figure 2.
D.hansenii 5-1-6 exhibited conjugation tubes;
T. delbrueckii 3-16-1,
Z. bailii 24-1-25,
S. cerevisiae PDA W 10, and
H. uvarum 9-2-1 differentiated spores [
55,
56,
57].
Figure 3 reports on the microscopic observation of selected strains grown on sodium acetate agar.
Figure 2.
Optical microscopy of representative strains: (a) C. dubliniensis CCY 29-178-1, (b) D. hansenii 5-1-6, (c) H. uvarum 9-2-1, (d) L. thermotolerans 5-1-3, (e) M. aff. chrysoperlae 11-1-4, (f) M. pulcherrima 125/14, (g) M. pulcherrima 11-1-7, (h) M. guilliermondii 12-5-1, (i) P. fermentans 12-4-4, (l) P. kluyveri PDA W 9, (m) S. cerevisiae 60/16, (n) T. delbrueckii 21-1-5, (o) T. delbrueckii 3-16-1, (p) Z. bailii 24-1-25. Magnification 40×; scale 20 µm.
Figure 2.
Optical microscopy of representative strains: (a) C. dubliniensis CCY 29-178-1, (b) D. hansenii 5-1-6, (c) H. uvarum 9-2-1, (d) L. thermotolerans 5-1-3, (e) M. aff. chrysoperlae 11-1-4, (f) M. pulcherrima 125/14, (g) M. pulcherrima 11-1-7, (h) M. guilliermondii 12-5-1, (i) P. fermentans 12-4-4, (l) P. kluyveri PDA W 9, (m) S. cerevisiae 60/16, (n) T. delbrueckii 21-1-5, (o) T. delbrueckii 3-16-1, (p) Z. bailii 24-1-25. Magnification 40×; scale 20 µm.
3.3. Yeast Screening
All strains grew in YPD broth as dispersed cells, with the exception of the strain M. pulcherrima CCY 69-2-15, which exhibited growth with aggregated cells.
After two days of incubation in YPD broth, the quantity of CO2 produced ranged from none (empty Durham tubes) to large (almost-full Durham tubes). The strains M. guilliermondii 12-5-1 and D. hansenii 5-1-6 did not produce gas, while the strain C. dublinensis CCY 29-178-1 produced a small quantity. The strains belonging to the M. pulcherrima species (strains 11-1-7, 125/14 and CCY 69-2-15) and the strains T. delbrueckii 3-16-1 and 3-16-2, S. cerevisiae 60/16, 15-1-552, 53, PDA W 10, PDA M 1/1, L. thermotolerans 5-1-3 and 5-1-1, M. aff. chrysoperlae 11-1-4 showed moderate gas production (half-full Durham tubes), the strains M. pulcherrima 11-1-5, T. delbrueckii 21-1-5, 21-1-10, 24-1-13, Z. bailii 24-1-25, M. pulcherrima PDA W 11, H. uvarum 9-2-1 and 67/14, P. fermentans 12-4-5 and CCY 29-97-12 were characterized by above-average gas production (more than half-full Durham tubes), and the strains H. uvarum 26/17, P. fermentans 12-4-4, and P. kluyveri PDA W 9 exhibited large gas production (almost full Durham tubes). After three or more days, all strains showed a very large CO2 production (full Durham tubes) except the strains M. guilliermondii 12-5-1 and D. hansenii 5-1-6, which did not ferment. Moreover, after tube vortexing, the strains H. uvarum 67/14 and 26/17, P. fermentans 12-4-4 and 12-4-5, and P. kluyveri PDA W 9 produced thick and persistent foam.
Five out of twenty-nine strains exhibited veils: M. pulcherrima 125/14 (weak), P. fermentans 12-4-4 and 12-4-5, P. kluyveri PDA W 9 (abundant), P. fermentans CCY 29-97-12 (abundant and thick).
Concerning growth at 37 °C, the strains T. delbrueckii 3-16-1 and 3-16-2, D. hansenii 5-1-6, L. thermotolerans 5-1-1, M. aff. chrysoperlae 11-1-4, M. pulcherrima 11-1-5 and CCY 69-2-15, T. delbrueckii 21-1-5, 21-1-10, 24-1-13, Z. bailii 24-1-25, and H. uvarum 9-2-1, 26/17 and 67/14 were unable to grow. Strains showing moderate to intense growth were, in order: S. cerevisiae 53, C. dubliniensis CCY 29-178-1, M. pulcherrima 125/14, S. cerevisiae 60/16, 15-1-552, PDA W 10, and PDA M 1/1, P. fermentans 12-4-5, and PDA W 9 P. kluyveri. Strains that exhibited growth as poor pellets were M. pulcherrima PDA W 11 and P. fermentans 12-4-4, while the strains L. thermotolerans 5-1-3, M. pulcherrima 11-1-7, and M. guilliermondii 12-5-1 showed some clouding of the culture broth.
Concerning growth at 18 °C, all strains were able to grow to a certain degree; ordered from lowest to most intense growth: M. aff. chrysoperlae 11-1-4, S. cerevisiae 53, M. pulcherrima 125/14, S. cerevisiae PDA W 10, PDA M 1/1, L. thermotolerans 5-1-3, 5-1-1, H. uvarum 9-2-1, 67/14, 26/17, P. fermentans 12-4-4, 12-4-5, CCY 29-97-12, T. delbrueckii 3-16-1, 3-16-2, C. dubliniensis CCY 29-178-1, S. cerevisiae 60/16, 15-1-552, M. pulcherrima 11-1-5, 11-1-7, CCY 69-2-15 M. pulcherrima, T. delbrueckii 21-1-5, 21-1-10, 24-1-13, M. pulcherrima PDA W 11, P. kluyveri PDA W 9, D. hansenii 5-1-6, Z. bailii 24-1-25, and M. guilliermondii 12-5-1.
The ability of the strains to grow under the stressed conditions possibly occurring during must fermentation was studied to consider their potential application in vinification. All strains were able to grow well in an osmotic stress condition (300 g/L of glucose) and at pH 3.0.
Table 4 reports the biochemical activities of the twenty-nine strains tested.
Concerning ethanol tolerance after one day of incubation (
Table 4a), all strains grew well in the medium supplemented with 5% of ethanol, while differences were observed with increasing ethanol concentration. In particular, with 10% of ethanol three strains grew very well—
S. cerevisiae PDA M 1/1,
L. thermotolerans 5-1-3,
P. kluyveri PDA W 9. The strains that tolerated 12% of ethanol to various extents were those belonging to
S. cerevisiae,
L. thermotolerans,
M. pulcherrima 125/14,
P. kluyveri PDA W 9,
Z. bailii 24-1-25, and two strains of
T. delbrueckii. This trend was observed also in the presence of 15% of ethanol, with the exception of the strains
P. kluyveri PDA W9 and
Z. bailii 24-1-25, which did not grow.
After one day of incubation in media supplemented with increasing concentrations of SO
2 (
Table 4a),
S. cerevisiae strains showed good growth indicating full resistance (to 400 mg/L of metabisulphite), with the exception of the
S. cerevisiae 60/16 which did not experience good growth with more than 200 mg/L of metabisulphite. This strain did show good growth in media supplemented with 300 and 400 mg/L of metabisulphite after two and three days of incubation, respectively. Non-
Saccharomyces strains showed marked differences in a strain-dependent manner. The strains belonging to
Lachancea,
Debaryomyces,
Hanseniaspora, and
Meyerozyma genera exhibited no growth even at the lowest SO
2 concentration. Some of the strains needed longer incubations to confirm their incapability to grow in presence of SO
2 or to resist at different concentrations. As example,
L. thermotolerans 5-1-1 grew after two days of incubation in the presence of 100 mg/L of metabisulphite, while at the highest SO
2 concentration only
P. kluyveri PDA W 9 and the above mentioned
S. cerevisiae 60/16 improved their growth over the incubation period.
All eleven strains chosen for the microvinification trials exhibited good growth in the presence of 80 mg/L of metabisulphite.
All strains were catalase-positive, with non-
Saccharomyces strains exhibiting the highest activity, especially strains belonging to the species
T. delbrueckii,
D. hansenii,
M. pulcherrima,
H. uvarum, and
P. fermentans (
Table 4b).
Only 6.9% of the strains were positive for acetic acid production. These belonged to the species
H. uvarum (
Figure 4).
The strains exhibited a wide range of H
2S production with the biomass color ranging from white to black and passing through intermediate tints (
Figure 5). The majority of the strains (41.38%) had hazel biomass followed by dark hazel (37.93%), black (13.79%), pale hazel (3.45%), and white (3.45%) (
Table 4a).
Thirty-one percent of the strains exhibited light to strong β-glucosidase activity (
Figure 6). The highest activity was recorded for strains belonging to the genus
Metschnikowia and the strain
P. kluyveri PDA W 9 (
Table 4b).
All strains grew on the medium supplemented with pectin. The strains
C. dublinensis CCY 29-178-1,
P. fermentans 12-4-4 and CCY 29-97-12 exhibited wider biomass spots. Moreover, 13 out of 29 strains exhibited a halo around the biomass after flooding with Lugol’s solution (
Table 4b). Shortly after washing, the strongest halos remained visible while the faint ones rapidly disappeared (
Figure 7).
The esterase activity of strains ranged from absent to strong (
Figure 8). Only
C. dubliniensis CCY 29-178-1,
M. aff.
chrysoperlae 11-1-4 and
M. pulcherrima 11-1-5 exhibited high esterase activity while two strains—
M. pulcherrima 125/14 and
M. guilliermondii 12-5-1—were characterized by moderate activity (
Table 4b).
A total of 58.62% of strains were positive for protease activity. Those with the highest activity were among the non-
Saccharomyces yeasts (
Metschnikowia,
Hanseniaspora, and
Pichia) (
Table 4b;
Figure 9).
Eleven of the twenty-nine strains—
D. hansenii 5-1-6,
H. uvarum 26/17,
L. thermotolerans 5-1-1,
M. pulcherrima 125/14,
M. pulcherrima 11-1-7,
S. cerevisiae 15-1-552,
S. cerevisiae 53,
S. cerevisiae PDA W 10,
S. cerevisiae PDA M 1/1,
T. delbrueckii 3-16-1,
Z. bailii 24-1-25—were chosen for micro-fermentation trials considering the results of the screening tests. The choice was made balancing the screening parameters’ results for each strain while also taking into account the possibility of further improving their characteristics through different techniques, such as hybridization. In detail, the strains chosen exhibited no or very low acetic acid production, low to medium H
2S production, good ethanol and SO
2 tolerance after one or two days, and a varied range of catalase, β-glucosidase, esterase, pectinase, and protease activities (
Table 4).
3.4. Enological Characterization by Micro-Fermentations
The eleven strains selected through the screening process were tested using micro-fermentations in order to evaluate their fermentation performance. The non-
Saccharomyces strains showed lower fermentation vigor than the
S. cerevisiae strains, which exhibited the highest fermentation vigor. Similar observations were reported for
M. pulcherrima 125/14. The lowest values reported were for
D. hansenii 5-1-6. Similar results were reported for fermentation vigor without and with SO
2, confirming the results obtained by screening on plates and indicating the resistance of the strains to the used SO
2 concentration (
Table 5).
Table 6,
Table 7 and
Table 8 show the physicochemical parameters of the wines produced using the eleven selected yeast strains. pH, TTA, and volatile acidity values for the wines produced with each strain are reported in
Table 6. All produced wines had a pH higher than the un-inoculated musts, and the TTA values were linearly correlated to pH. The pH range for the trials without SO
2 was 3.34–3.48, while for the trials with SO
2 it was 3.29–3.44. The volatile acidity ranged from 0.12 to 1.68 g/L of acetic acid in the absence of SO
2.
Concerning ethanol production (
Table 7),
S. cerevisiae strains consumed glucose and fructose as expected, with produced ethanol percentages as high as 8.39% and 8.23% by
S. cerevisiae 15-1-552 without SO
2 and
S. cerevisiae PDA W10 with SO
2, respectively.
M. pulcherrima 11-1-7 fermented 33 and 30 g/L of glucose in micro-fermentation without and with SO
2, respectively, and 23 and 19 g/L of fructose in micro-fermentation without and with SO
2, respectively, producing the lowest percentages of ethanol (4.15% and 4.10% without and with SO
2).
L. thermotolerans 5-1-1 fermented 80 g/L of glucose in trials without SO
2 and consumed almost all of the glucose in trials with SO
2; it fermented 70 and 81 g/L of fructose in the absence and presence of SO
2, respectively, producing the highest values of ethanol (approximately 7.15–7.25%). Moreover,
T. delbrueckii 3-16-1 produced wines with approximately 7% of ethanol. The lowest ethanol production was recorded for
D. hansenii 5-1-6.
Among the non-
Saccharomyces yeasts,
M. pulcherrima 11-1-7 produced wines with the highest glycerol concentration, followed by
Z. bailii 24-1-25, while the lowest concentration was produced by
D. hansenii 5-1-6 (
Table 8).
Comparing the total concentrations of polyphenols and flavonoids between the inoculated and un-inoculated musts (
Table 8), in wines without SO
2, increases or decreases in concentrations of polyphenol and flavonoid were reported in a strain-dependent manner. By contrast, in wines produced with SO
2, a decrease in concentration of flavonoids was observed for all strains tested (
Table 8).
During GC-MS analysis, various volatile aroma compounds were detected. Most of them are well known as contributors to wine aroma [
58,
59]. All fermented samples, with the exception of that fermented by
D. hansenii 5-1-6, contained high amounts of 2-phenylethanol, which is an established aroma compound with a sweet, floral, rosy character. The highest amounts of this compound were produced, among samples fermented with SO
2 (
Table S1), by
L. thermotolerans 5-1-1. Only samples fermented by
S. cerevisiae strains, together with that fermented by
M. pulcherrima 125/14, contained remarkable amounts of 4-vinylguaiacol, which is an aroma compound with a sweet-smoky character, typical for Traminer wines or for whisky. Various strains produced medium-chain fatty acids, a phenomenon more pronounced in samples with SO
2 (
Table S1). Several samples contained considerable amounts of pyran and furan derivatives, which were probably sourced or metabolized from the UHT-treated substrate. Dodecanoic acid was detected only in various fermented samples treated with SO
2, while only some fermented samples without SO
2 (
Table S2) contained propylene glycol, 4-cyclopentene-1,3-dione, diethyleneglycol ethylether, 2-methylthiolane, hexanoic acid and nonanoic acid.
4. Discussion
This contribution aimed to give a guide as comprehensive as possible to methods for wine yeast selection while studying our own strains. We decided to test the strains for all the characteristics to obtain for each of them a complete profile in view of possible genetic improvement. The simple trials used allowed us to exclude those strains possessing the worst features (alone or in combination) for wine-making—high acetic acid and H2S production, low ethanol and SO2 tolerance, foam production, zero or low enzymatic activity—selecting the best strains to test in must fermentations.
The strains here reported as
M. pulcherrima are to be considered
M. pulcherrima-like strains due to the difficulty in assigning an exact taxonomic position, as a result of a lack of distinctive morphological and physiological properties among species belonging to the
M. pulcherrima clade and the lack of rDNA barcode gaps [
60,
61,
62,
63]. In contrast to Sipiczki [
63], our strain of
M. aff.
chrysoperlae is a pigmented strain, as are all of our strains of
M. pulcherrima. In our study, since it is known that for taxonomical proposes it is necessary to use more gene markers in order to well classify yeast strains, we chose to use only ITS fragment sequencing as an identification tool in combination with the RFLP and FTIR approaches. The sequencing of ITS regions is suitable as a rapid and preliminary identification tool for yeasts, which can then be deeply taxonomically analyzed exploiting other molecular markers as shown by previous studies [
60,
61,
62,
63].
FTIR spectroscopy facilitates the grouping of yeasts based on the chemical composition of their cells. It is a high-throughput method requiring no chemicals to be used, and therefore is cheap and convenient. Our results presented in
Figure 1 demonstrate the overall success of this method to group yeast strains similarly to the sequencing-based approach, which is much more tedious and costly. Based on this, and based on our experience and several other studies [
40,
53,
54], we can recommend the use of FTIR spectroscopy for preliminary grouping of strains and reducing the number of strains in order to pass to further evaluation, by elimination of those that are most probably duplicates or multiplicates.
The initial yeast concentration used in the screening might differ among yeast strains and species due to different morphology and size; therefore, we compared each strain with its own control condition, avoiding the comparison of different yeast species.
The presence of sulfur off-flavor in wine as a result of yeast metabolism is negatively correlated to wine quality, as it is an undesired wine off-flavor, and it also gives rise to health concerns. The screening of yeast strains that produce zero or low H
2S is particularly necessary to take into account for the production of organic and sulfite-free wines. The degree of H
2S production by non-
Saccharomyces yeasts and the wide intra-species variability observed by different authors are consistent with the findings of this study [
28,
29,
64]. By contrast, our findings for
H. uvarum and
M. pulcherrima conflict with the results of Polizzotto et al. [
22] and Belda et al. [
65] who reported absent or low sulfite-reductase activity.
The ability of the non-
Saccharomyces strains under study to grow under stressed conditions was assayed to understand their potential application in vinification. The strains’ ability to grow at low pH and in high concentrations of glucose makes them suitable for harsh environments; in addition, their growth at different temperatures makes them suitable for red and white vinification. Our results confirm that
S. cerevisiae is the most ethanol-tolerant species compared to many non-
Saccharomyces. Concerning the non-
Saccharomyces strains, some of them exhibited higher ethanol tolerance (up to 12% or to a lesser extent up to 15%) compared to results from the literature [
28,
62,
63,
64,
66,
67,
68], confirming the results of Mukherjee et al. [
69] for
L. thermotolerans,
T. delbrueckii and
Z. bailii. The use of SO
2 in winemaking is mandatory to control spoilage and microorganisms and to protect wines from oxidation. Therefore, it is important for wine yeasts to be able to tolerate SO
2 at the dosage commonly used for commercial wine fermentation; on the other hand, the health aspect has to be taken into account. For this reason, although all strains were tested at increasing concentrations of SO
2 (100–400 mg/L), the microvinification trials were carried out using a low SO
2 concentration (80 mg/L). Yeasts belonging to
Torulaspora,
Metschnikowia,
Zygosaccharomyces, and
Lachancea genera were less sensitive to SO
2 than commonly considered [
23] and this is consistent with other authors’ results [
28,
29]. Concerning the strains’ contribution to the pH of wine, our strain of
L. thermotolerans confirms the existing strains’ variability in producing lactic acid and consuming malic acid [
66]. The selected
L. thermotolerans strain did not significantly influence pH and total acidity compared to the
S. cerevisiae controls (53, PDA W 10, PDA M1/1) (
Table 6). Previous studies report variability in lactic acid production from 0.2 g/L to approximately 10 g/L and reductions in pH from insignificant differences to 0.5 [
70,
71,
72]. However, many other quality parameters can be improved by
L. thermotolerans, so the choice of strain can be interesting. Results from the catalase test gave information on the ability of strains to cope with oxidative stress and to perform better during fermentation [
73]. All of the strains tested in this study were catalase positive to various extents and in agreement with other authors for
H. uvarum,
Candida,
Pichia,
D. hansenii,
M. pulcherrima [
27,
28].
The wine industry makes use of protease and pectinase to prevent wine haze and facilitate wine clarification, together with glycosidase to favor the expression of grape varietal aromas [
74]. Wine yeasts can possess one or more natural enzymatic activities useful for vinification [
32,
61,
75,
76,
77]. Yeast enzymes of interest include esterases, glycosidases, proteases, and cellulases able to hydrolyze structural components [
78,
79] that determine, based on their presence and intensity, the sensorial complexity of wines [
80].
Our results regarding β-glucosidase, which breaks down glycosidic complexes releasing terpenes and other volatile compounds, in our selected yeast strains are consistent with other authors reporting high β-glucosidase incidence in
Debaryomyces and
Pichia [
65,
77,
81] and especially in
M. pulcherrima, mostly in a strain-dependent manner [
28,
29,
32,
65,
77,
81,
82,
83]. Our strains positive for esterase, which hydrolyzes long-chain esters, belonged to the genera
Candida,
Meyerozyma, and
Metschnikowia, in agreement with other studies [
29,
84]. The protease activity was strongest in our strains of
H. uvarum,
L. thermotolerans,
M. pulcherrima,
Pichia spp.,
T. delbrueckii, and
S. cerevisiae and these results were in agreement with other studies [
27,
28,
32,
65,
85,
86,
87] while they were in conflict with Comitini et al. [
29] who reported no strains of
L. thermotolerans,
M. pulcherrima,
T. delbrueckii, and
S. cerevisiae exhibiting any protease activity. Similar negative protease
S. cerevisiae strains were reported by Charoenchai et al. [
33]. Some authors reported no yeasts (including
Candida,
Debaryomyces,
Hanseniaspora,
Metschnikowia,
Pichia,
Saccharomyces,
Torulaspora) possessing pectinolytic activity [
33,
77]. Indeed, pectinolytic activity is rarely found in wine-related yeasts but it is reported in
Candida,
M. pulcherrima,
L. thermotolerans,
T. delbrueckii,
H. uvarum, and
S. cerevisiae [
21,
27,
82,
88] and our results were in agreement with these authors.
Fermentation vigor is a good indicator of the strain’s promptness and of the progress of the fermentation. It is easy to monitor as a weight measurement, which is directly proportional to sugar consumption and ethanol synthesis, determining the fermentation power. As expected, the
S. cerevisiae strains had higher fermentation vigor than the non-
Saccharomyces strains, in agreement with Caridi et al. 2002 [
20], with the exception of the
M. pulcherrima 125/14 strain. This strain, in fact, had higher fermentation vigor than the usually reported 4.5% ethanol (
v/
v) [
89]. However, it is reported that some strains of
M. pulcherrrima can produce 9–11.5% ethanol [
90], with an ethanol tolerance of at least 6% with a few exceptions above 9% [
28].
Acetic acid is one of the compounds that impact the sensory profile of wine, contributing to definitions of its quality. An acetic acid concentration of 0.7–1.1 g/L is considered unpleasant; the maximum acceptable limit for volatile acidity in most wines is 1.2 g/L of acetic acid [
91,
92]. Values in the range 0.2–0.7 g/L are usually considered optimal [
91]. Although most non-
Saccharomyces are considered high acetic acid producers [
93,
94] other evidence indicates
T. delbrueckii,
L. thermotolerans,
M. pulcherrima as low producers [
29,
95,
96,
97,
98,
99]. Our results were consistent with these reports, with all selected being within the optimal range with the exception of
H. uvarum 26/17, the highest producer as reported for the species by Aponte and Blaiotta [
99]. However, the behavior of this strain confirmed the utility of the visible halo as a screening test [
16,
77,
100].
The quality of wine is also linked to the glycerol concentration, although this has recently been contested [
101]. Noble and Bursick [
102] indicated 5.2 g/L as the taste threshold with a maximum acceptable level of 25 g/L [
103]. It is usually reported that glycerol production is higher in wines fermented with non-
Saccharomyces compared to those produced with
S. cerevisiae [
101]. In addition, Zhu et al. [
104] reported higher glycerol concentration for non-
Saccharomyces than for
S. cerevisiae, which was in agreement with the results of the majority of our tested strains. The role of this metabolite must be considered taking into account its relationship with ethanol and acetic acid production. In fact, higher glycerol production could result in a reduction in ethanol production [
105] and a higher production of acetic acid [
106].
The role of phenolics in wine is related to the sensorial and health aspects. The effect of SO
2 in vinification is well known [
107] as is the contribution of
S. cerevisiae to the polyphenolic profile of wine [
108,
109,
110,
111,
112,
113]. Recently, Morata et al. [
114] reported different antocyanin adsorption by non-
Saccharomyces with the goal of improving the color stability of wine. The different polyphenols concentrations in wines produced by our tested yeasts could be attributable to the strain (production of metabolites and cell wall adsorption) used in wines produced without SO
2 and to the concurrent role of strain and SO
2 in wines produced with the addition of SO
2.
Analysis of volatile compounds using GC-MS aimed to determine the production of known and described aroma-active compounds by individual yeast strains. Although the aroma character of some of the compounds has been described as “pleasant“ and their presence in wine is often appreciated, those described as “unpleasant” (or off-flavors) may be very important to achieve the required complexity, fullness and/or typicality of a wine aroma, when present at appropriate concentrations and in certain combinations. Lists of common aroma-active compounds in various types of wine are available in the literature, which facilitates their tracing in experimental samples. However, interpretation of the analytical data need not be straightforward and usually requires combination with sensorial evaluation of the wine bouquet [
58,
59].
Based on their performance, we propose
S. cerevisiae PDA W 10,
L. thermotolerans 5-1-1 and
M. pulcherrima 125/14 as potential wine starters. Due to the characteristics of
L. thermotolerans and
M. pulcherrima, these yeasts are normally used in mixed or sequential fermentations together with
S. cerevisiae [
66,
114] in order to complete the fermentation process, guaranteeing the quality of the wine.
S. cerevisiae PDA W 10 could be used as pure inoculum. Moreover, after further studies on competitive abilities of the strains and examination of the killer trait of
S. cerevisiae strains,
L. thermotolerans 5-1-1,
M. pulcherrima 125/14, and
S. cerevisiae PDA W 10 could be used as co- or sequential inocula. It must be highlighted that the
M. pulcherrima 125/14 strain has interesting properties, such as its fermentation vigor, that allows for the consideration of the use of this strain as pure inoculum as well.
The step-by-step process for screening and selecting wine yeasts is as follows: yeast isolation/revitalization of stored yeasts, yeasts identification, Petri plate screening for useful enological characteristics, evaluation of results and choice of strains, use of the chosen strains for micro-vinification, analyses of the produced wines, evaluation of results and identification of wine starter strains.